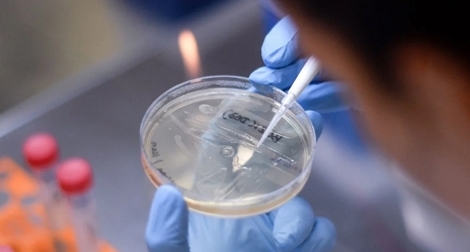
Con đường tìm vaccine trị COVID-19: Trở ngại thiếu tiền

Vào ngày 16/4/2025 vừa qua, hãng dược phẩm Glenmark Pharmaceuticals (Ấn Độ) quyết định thu hồi 39 loại thuốc của hãng đang lưu hành trên thị trường Mỹ, trong đó có các sản phẩm thuốc chữa động kinh, tiểu đường, đa xơ cứng và những bệnh tim mạch khác.
#dược phẩm
Tổng thống Mỹ Donald Trump ngày 18/2 cho biết rằng ông có ý định áp thuế ô tô “khoảng 25%” cũng như các loại thuế tương tự đối với chất bán dẫn và dược phẩm nhập khẩu.
Nhà máy sản xuất vaccine và sinh phẩm VNVC được Tập đoàn Rieckermann (Đức) thiết kế xây dựng theo công nghệ hiện đại hàng đầu thế giới hướng đến mục tiêu Net Zero - giảm lượng phát thải khí nhà kính xuống bằng 0.
Trường Đại học Phenikaa vừa tổ chức Lễ ký kết Biên bản ghi nhớ hợp tác với Viện Vật lý Hóa học Lan Châu (LICP), thuộc Viện Hàn lâm Khoa học Trung Quốc (CAS). Sự kiện nhằm tăng cường nghiên cứu và trao đổi kiến thức trong các lĩnh vực hợp chất tự nhiên, khám phá thuốc và phát triển khoa học.
Ngày 28/5, ông Cao Thanh Bình, Trưởng ban Văn hóa - Xã hội Hội đồng nhân dân (VH-XH HĐND) TP Hồ Chí Minh đã thông tin về dự thảo báo cáo kết quả khảo sát về công tác quản lý và sử dụng thuốc tại các cơ sở khám, chữa bệnh (KCB), cơ sở kinh doanh dược trên địa bàn thành phố.
Ban Chỉ đạo 389 Hà Nội vừa ban hành công văn về việc thành lập 2 đoàn kiểm tra liên ngành đối với mặt hàng thực phẩm, mỹ phẩm, dược phẩm trên địa bàn.
Nhiều hãng dược phẩm trên thế giới đang lên kế hoạch phát triển các bộ xét nghiệm bệnh đậu mùa khỉ, trong bối cảnh chính phủ một số nước tăng cường theo dõi đợt bùng phát dịch bên ngoài khu vực châu Phi.
®Không sao chép dưới mọi hình thức khi chưa có sự đồng ý bằng văn bản của Báo Công An Nhân Dân.